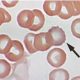

NNPA NEWSWIRE — President Biden’s Justice40 initiative. This executive order ensures that 40% of federal investment benefits flow to disadvantaged communities, addressing deep-seated inequities.

NNPA NEWSWIRE — The White House said the EPA's proposal goes beyond mere lead service line replacements, incorporating stringent measures such as enhanced tap water sampling...


Let’s set the record straight. The Environmental Protection Agency (EPA) has authorized the shipment of millions of tons of coal throughout the Bay Area for years....